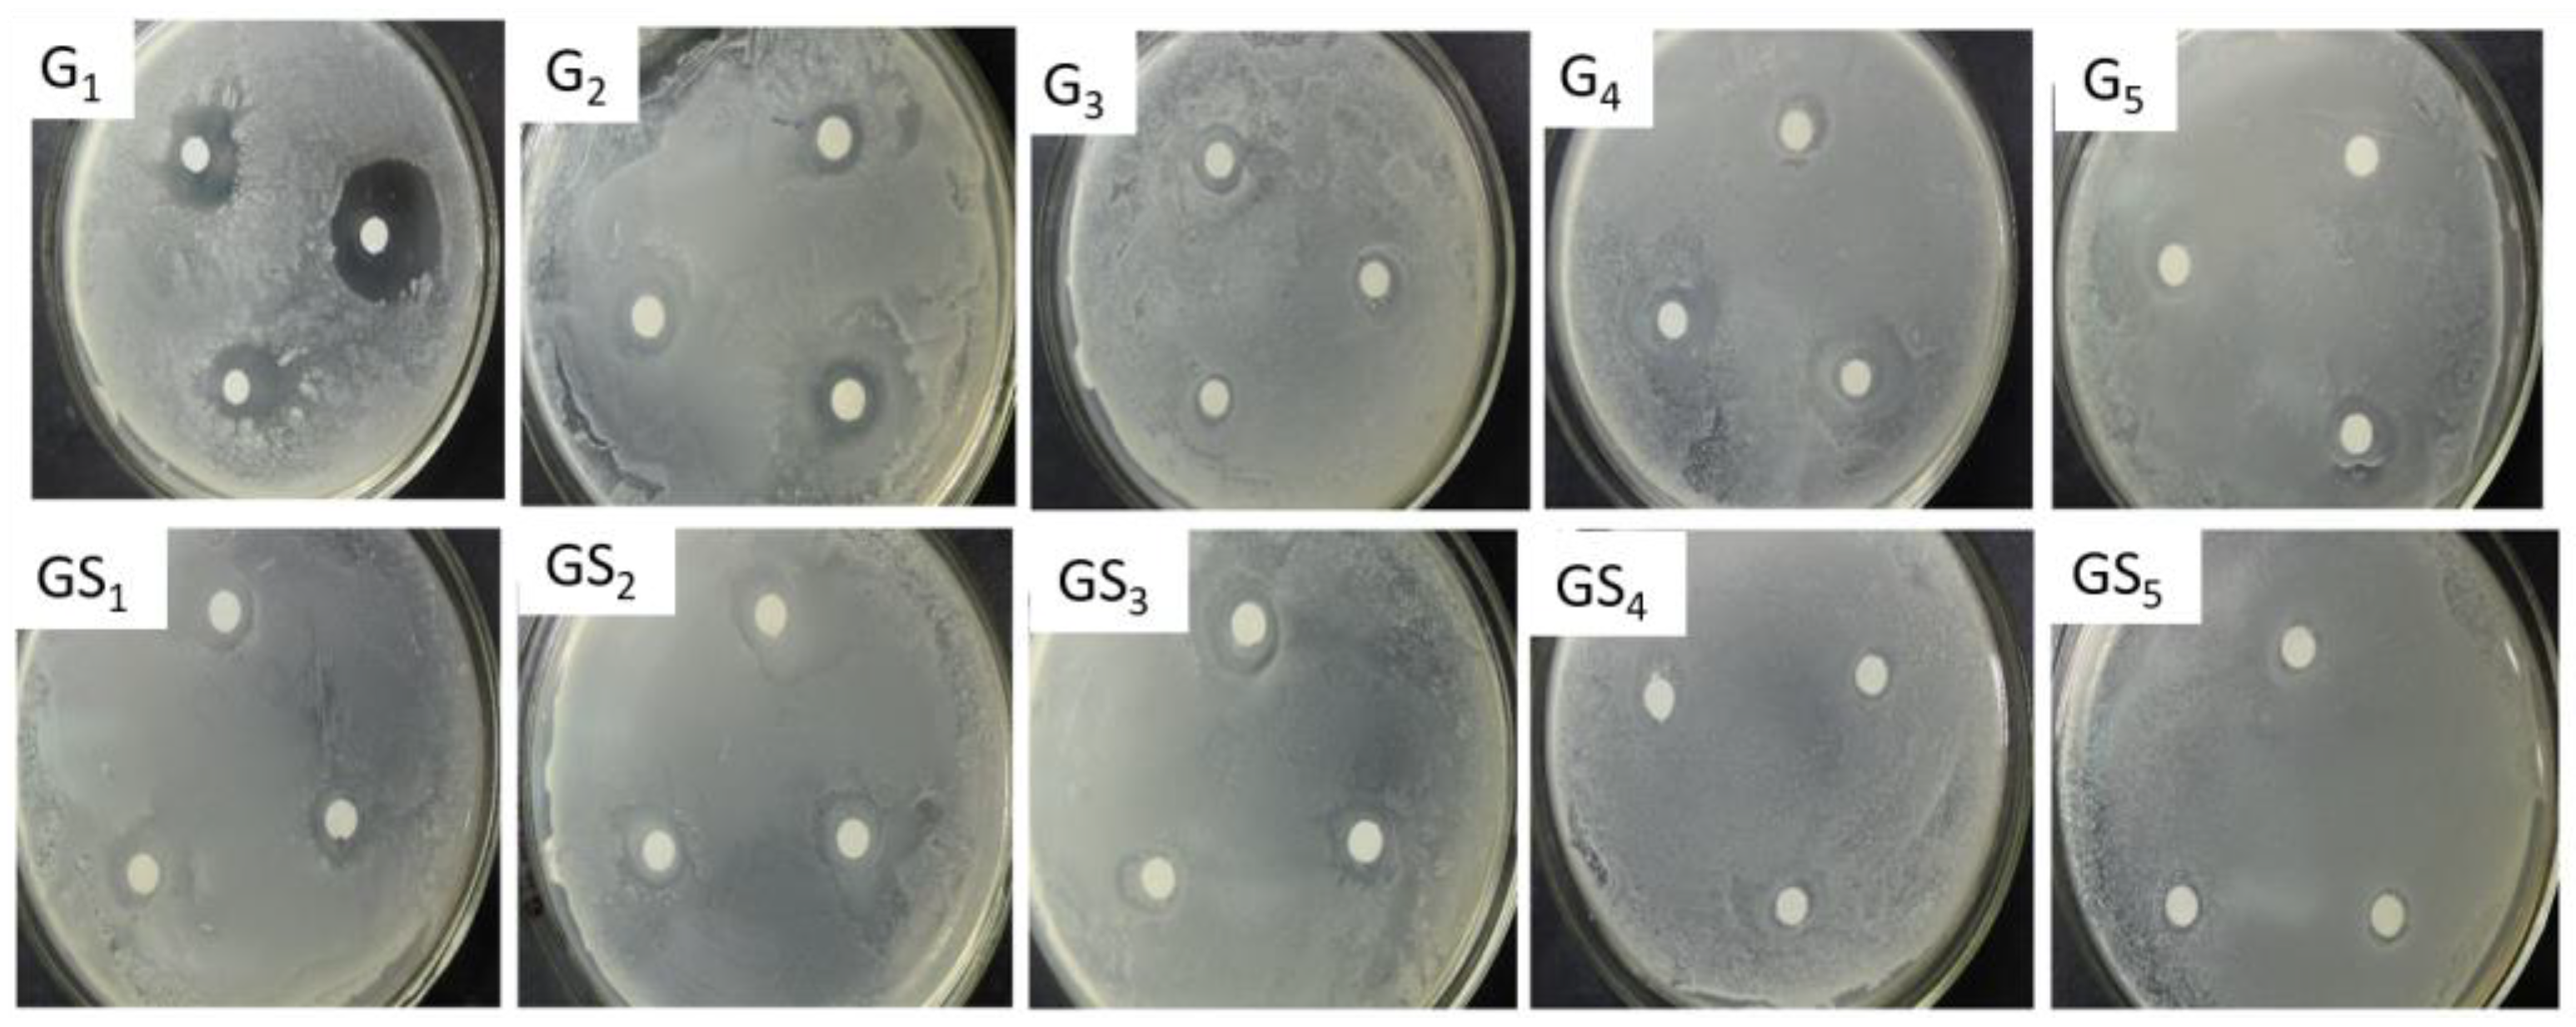
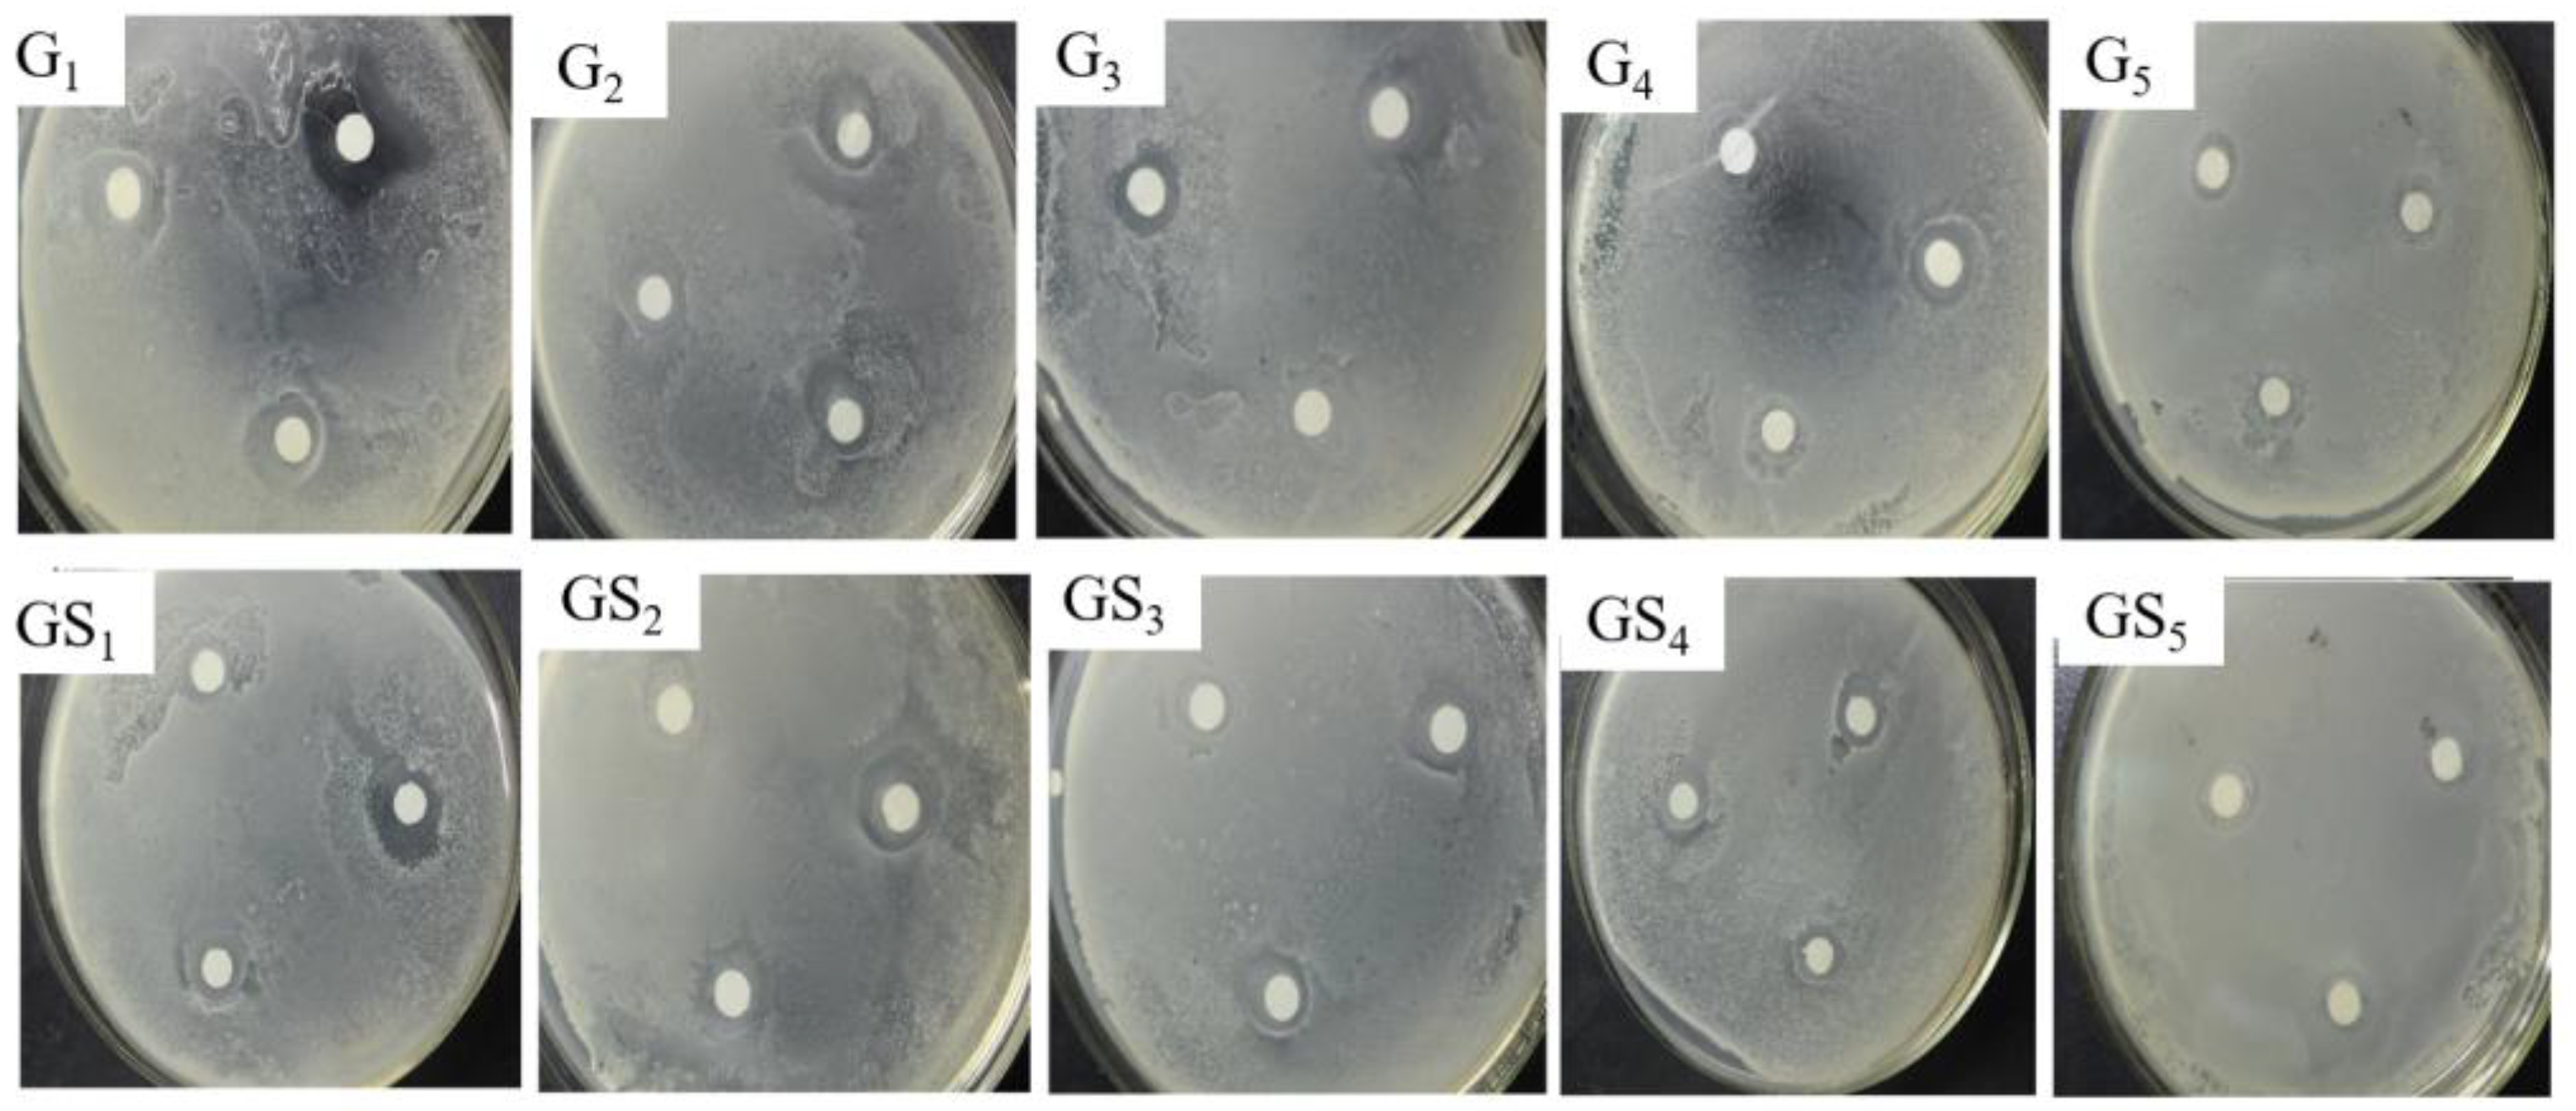

Synthesis and Antibacterial Properties of Oligomeric Dehydrogenation Polymer from Lignin Precursors
Abstract
:1. Introduction
2. Results and Discussion
2.1. 13C-NMR Spectral Analysis of DHPs
2.2. Molecular Weight Analysis of DHP
2.3. Analysis of Antibacterial Properties of DHP Fractions
2.4. Analysis of Antibacterial Properties of Purified Components of DHP
2.5. Structural Analysis of Bioactive Purified DHP Compounds by Mass Spectrometry
3. Materials and Methods
3.1. Materials
3.2. Synthesis of DHP
3.3. Classification of the DHP
3.4. 13C-NMR Measurement of DHP-G and DHP-GS
3.5. Determination of Molecular Weight of the DHP Fractions
3.6. Purification of Ether Fraction of DHP with Preparative Column Chromatography
3.7. Determination of the Antibacterial Activity of DHP Fractions and Purified Compounds
3.8. Mass Spectrometry Analysis of the Structure of the Purified DHP Compounds
4. Conclusions
- DHP-G and DHP-GS were synthesised by laccase-catalysed dehydrogenation polymerisation. The 13C-NMR spectra showed that both DHP-G and DHP-GS contained β-O-4, β-5, β-β, β-1, and 5-5 substructures.
- The ether-soluble fractions C12 of DHP-G and C22 of DHP-GS had strong antibacterial activities against E. coli and S. aureus.
- The antibacterial activities of compounds GS1–GS5 purified from the C22 fraction and compounds G1–G5 separated from the C12 fraction were stronger against E. coli than S. aureus. The separated compounds G1, G2, G3, and GS1 had strong inhibitory effects against E. coli and S. aureus.
- According to the results of APCI-MS, compound G1 was a (β-5) G-type dimer, while compound G2 was a (β-5) (β-5) G-type trimer, and G3 was a (β-O-4) (β-5) (β-5) G-type tetramer. GS1 was a (β-5) GS-type dimer.
- Higher molecular weight and the introduction of syringyl units reduced the antibacterial activity. The antibacterial activity of G1, which had the best antibacterial activity, is attributable to the β-5-type connected phenylcoumaran dimer.
Author Contributions
Funding
Institutional Review Board Statement
Informed Consent Statement
Data Availability Statement
Conflicts of Interest
Sample Availability
References
- Brianna, M.; Andrea, M. Strategies for the Conversion of Lignin to High-Value Polymeric Materials: Review and Perspective. Chem. Rev. 2016, 116, 2275–2306. [Google Scholar]
- Gillet, S.; Aguedo, M.; Petitjean, L.; Morais, A.R.C.; Costa Lopes, A.M.D.; Łukasik, R.M.; Anastas, P.T. Lignin Transformations for High Value Applications: Towards Targeted Modifications Using Green Chemistry. Green Chem. 2017, 19, 4200–4233. [Google Scholar] [CrossRef]
- Parit, M.; Jiang, Z. Towards lignin derived thermoplastic polymers. Biol. Macromol. 2020, 165, 3180–3197. [Google Scholar] [CrossRef]
- Fortunati, E.; Yang, W.; Luzi, F.; Kenny, J.; Torre, L.; Puglia, D. Lignocellulosic nanostructures as reinforcement in extrudedand solvent casted polymeric nanocomposites: An overview. Eur. Polym. 2016, 80, 295–316. [Google Scholar] [CrossRef]
- Wu, W.; Dutta, T.; Varman, A.M.; Eudes, A.; Manalansan, B.; Loqué, D.; Singh, S. Lignin valorization: Two hybrid biochemical routes for the conversion of polymeric lignin into value-added chemicals. Sci. Rep. 2017, 7, 8420. [Google Scholar] [CrossRef] [PubMed] [Green Version]
- Figueiredo, P.; Lintinen, K.; Hirvonen, J.T.; Kostiainen, M.A.; Santos, H.A. Properties and chemical modifications of lignin: Towards lignin-based nanomaterials for biomedical applications. Prog. Mater. Sci. 2018, 93, 233–269. [Google Scholar] [CrossRef]
- Sláviková, E.; Košíková, B. Inhibitory effect of lignin by-products of pulping on yeast growth. Folia Microbiol. 1994, 39, 241–243. [Google Scholar] [CrossRef]
- Thakur, V.K.; Thakur, M.K. Recent advances in green hydrogels from lignin: A review. Biol. Macromol. 2015, 72, 834–847. [Google Scholar] [CrossRef]
- Asina, F.; Brzonova, I.; Kozliak, E.; Kubátová, A.; Jin, Y. Microbial treatment of industrial lignin: Successes, problems and challenges. Renew. Sustain. Energy Rev. 2017, 77, 1179–1205. [Google Scholar] [CrossRef]
- Guo, M.; Tony, J.; Nghiem, N.P.; Fan, X.; Phoebe, X.Q.; Jang, C.; Shao, L.; Wu, C. Assessment of Antioxidant and Antimicrobial Properties of Lignin from Corn Stover Residue Pretreated with Low-Moisture Anhydrous Ammonia and Enzymatic Hydrolysis Process. Appl. Biochem. Biotechnol. 2018, 184, 350–365. [Google Scholar] [CrossRef]
- Maia, R.A.; Ventorim, G.; Batagin-Neto, A. Reactivity of lignin subunits: The influence of dehydrogenation and formation of dimeric structures. Mol. Model. 2019, 25, 228. [Google Scholar] [CrossRef] [PubMed]
- Feneley, R.C.L.; Hopley, I.B.; Wells, P.N.T. Urinary catheters: History, current status, adverse events and research agenda. Med. Eng. Technol. 2015, 39, 459–470. [Google Scholar] [CrossRef] [PubMed] [Green Version]
- Domínguez-Robles, J.; Larrañeta, E.; Fong, M.L.; Martin, N.K.; Irwin, N.J.; Mutjé, P.; Tarrés, P.; Delgado-Aguilar, M. Lignin/Poly (bu-tylene succinate) composites with antioxidant and antibacterial properties for potential biomedical applications. Biol. Macromol. 2020, 145, 92–99. [Google Scholar] [CrossRef] [PubMed]
- Kaur, R.; Uppal, S.K.; Sharma, P. Antioxidant and Antibacterial Activities of Sugarcane Bagasse Lignin and Chemically Modified Lignins. SugarTech 2017, 19, 675–680. [Google Scholar] [CrossRef]
- Freudenberg, K.; Hübner, H.H. Oxyzimtalkohole und ihre Dehydrierungs polymerisate. Chem. Ber. 1952, 85, 1181–1191. [Google Scholar] [CrossRef]
- Zheng, L.; Lu, G.; Pei, W.; Yan, W.; Li, Y.; Zhang, L.; Huang, C.; Jiang, Q. Understanding the relationship between the structural properties of lignin and their biological activities. Biol. Macromol. 2021, 190, 291–300. [Google Scholar] [CrossRef]
- Xu, Y.; Zeng, P.; Li, M.; Bian, J.; Peng, F. γ-Valerolactone/water system for lignin fractionation to enhance antibacterial and antioxidant capacities. Sep. Purif. Technol. 2021, 279, 119780. [Google Scholar] [CrossRef]
- Rocca, D.M.; Vanegas, J.P.; Fournier, K.; Becerra, M.C.; Scaiano, J.C.; Lanterna, A.E. Biocompatibility and photo-induced antibacterial activity of lignin-stabilized noble metal nanoparticles. RSC Adv. 2018, 8, 40454–40463. [Google Scholar] [CrossRef] [Green Version]
- Marulasiddeshwara, M.B.; Dakshayani, S.S.; Kumar, M.N.S.; Chethana, R.; Kumar, P.R.; Devaraja, S. Facile-one pot-green synthesis, antibacterial, antifungal, antioxidant and antiplatelet activities of lignin capped silver nanoparticles: A promising therapeutic agent. Mater. Sci. Eng. C 2017, 81, 182–190. [Google Scholar] [CrossRef]
- Lourençon, T.V.; de Lima, G.G.; Ribeiro, C.S.; Hansel, F.A.; Maciel, G.M.; da Silva, K.; Winnischofer, S.M.B.; de Muniz, G.I.B.; Magalhães, W.L.E. Antioxidant, antibacterial and antitumoural activities of kraft lignin from hardwood fractionated by acid precipitation. Biol. Macromol. 2021, 166, 1535–1542. [Google Scholar] [CrossRef]
- Guan, S.; Mlynár, J.; Sarkanen, S. Dehydrogenative polymerization of conifery alcohol on macromolecular lignin templates. Phytochemistry 1997, 45, 911–918. [Google Scholar]
- Terashima, N.; Atalla, R.H.; Ralph, S.A.; Landucci, L.L.; Lapierre, C.; Monties, B. New Preparations of Lignin Polymer Models under Conditions that Approximate Cell Wall Lignification. I. Synthesis of Novel Lignin Polymer Models and their Structural Characterization by 13C NMR. Holzforschung 1995, 49, 521–527. [Google Scholar] [CrossRef]
- Fournand, D.; Cathala, B.; Lapierre, C. Initial steps of the peroxidase-catalyzed polymerization of coniferyl alcohol and/or sinapyl aldehyde: Capillary zone electrophoresis study of pH effect. Phytochemistry 2003, 62, 139–146. [Google Scholar] [CrossRef]
- Yanez, A.J.; Li, W.; Mabon, R.; Broadbelt, L.J. A Stochastic Method to Generate Libraries of Structural Representations of Lignin. Energy Fuels 2016, 30, 5835–5845. [Google Scholar] [CrossRef]
- Zhao, Z.; Liu, Z.; Pu, Y.; Meng, X.; Xu, J.; Yuan, J.; Ragauskas, A.J. Emerging Strategies for Modifying Lignin Chemistry to Enhance Biological Lignin Valorization. ChemSusChem 2020, 20, 5423–5432. [Google Scholar] [CrossRef]
- Shu, F.; Jiang, B.; Yuan, Y.; Li, M.; Wu, W.; Jin, Y.; Xiao, H. Biological Activities and Emerging Roles of Lignin and Lignin-Based Products—A Review. Biomacromolecules 2021, 22, 4905–4918. [Google Scholar] [CrossRef]
- Ye, Z.; Xie, Y.; Wu, C.; Wang, P.; Le, X. Dehydrogenation polymerization of isoeugenol and formation of lignin-carbohydrate complexes with presence of polysaccharide. Chem. Ind. For. Prod. 2016, 36, 45–50. [Google Scholar]
- Salanti, A.; Orlandi, M.; Tolppa, E.L.; Zoia, L. Oxidation of Isoeugenol by Salen Complexes with Bulky Substituents. Int. J. Mol. Sci. 2010, 11, 912–926. [Google Scholar] [CrossRef] [Green Version]
- Chen, X.; Zhao, H.; Wu, H.; Ye, Z.; Xie, Y. Preparation and antioxidant properties of dehydrogenation polymer of isoeugenol. Chem. Ind. For. Prod. 2018, 38, 87–92. [Google Scholar]
- Xie, Y.; Yasuda, S.; Wu, H.; Liu, H. Analysis of the structure of lignin-carbohydrate complexes by the specific 13C tracer method. Wood Sci. 2000, 46, 130–136. [Google Scholar] [CrossRef]
- Holtman, K.M.; Chang, H.; Kadla, J.F. Solution-state nuclear magnetic resonance study of the similarities between milled wood lignin and cellulolytic enzyme lignin. Agric. Food Chem. 2004, 52, 720–726. [Google Scholar] [CrossRef] [PubMed]
- Lindfors, C.; Mäki-Arvela, P.; Paturi, P.; Aho, A.; Eränen, K.; Hemming, J.; Peurla, M.; Kubička, D.; Simakova, I.L.; Murzin, D.Y. Hydrodeoxygenation of Isoeugenol over Ni- and Co-Supported Catalysts. ACS Sustain. Chem. Eng. 2019, 7, 14545–14560. [Google Scholar] [CrossRef] [Green Version]
- Ahn, J.; Avonto, C.; Chittiboyina, A.G.; Khan, I.A. Is Isoeugenol a Prehapten? Characterization of a Thiol-Reactive Oxidative Byproduct of Isoeugenol and Potential Implications for Skin Sensitization. Chem. Res. Toxicol. 2020, 33, 948–954. [Google Scholar] [CrossRef] [PubMed]
- Hage, R.E.; Brosse, N.; Chrusciel, L.; Sanchez, C.; Sannigrahi, P.; Ragauskas, A. Characterization of milled wood lignin and ethanol organosolv lignin from miscanthus. Polym. Degrad. Stab. 2009, 94, 1632–1638. [Google Scholar] [CrossRef]
- Lüdemann, H.D.; Nimz, H.H. Carbon-13 nuclear magnetic resonance spectra of lignins. Biochem. Biophys. Res. Commun. 1973, 52, 1162–1169. [Google Scholar] [CrossRef]
- Nimz, H.H.; Tschirner, U.; Stähle, M.; Lehmann, R.; Schlosser, M. Carbon-13 NMR Spectra of Lignins, 10.1 Comparison of Structural Units in Spruce and Beech Lignin. Wood Chem. Technol. 1984, 4, 265–284. [Google Scholar] [CrossRef]
- McElroy, R.D.; Lai, K. Fractionation-purification, IR, 1H 13C NMR spectral and property studies of an industrial based sludge lignin. Wood Chem. Technol. 1988, 8, 361–378. [Google Scholar] [CrossRef]
- Xie, Y.; Robert, D.R.; Terashima, N. Selective carbon 13 enrichment of side chain carbons of ginkgolignin traced by carbon 13 nuclear magnetic resonance. Plant Physiol. Biochem. 1994, 32, 243–249. [Google Scholar]
- Harman-Ware, A.E.; Happs, R.M.; Davison, B.H.; Davis, M.F. The effect of coumaryl alcohol incorporation on the structure and composition of lignin dehydrogenation polymers. Biotechnol. Biofiuels 2017, 10, 281. [Google Scholar] [CrossRef] [Green Version]
- Xie, Y.; Terashima, N. Selective Carbon 13-Enrichment of Side Chain Carbons of Ginkgo Lignin Traced by Carbon 13 Nuclear Magnetic Resonance*. Mokuzai Gakkaishi 1991, 37, 935–941. [Google Scholar]
- Lapierre, C.; Monties, B.; Guittet, E.; Lallemand, J.Y. Photosynthetically 13C-Labelled Poplar Lignins: 13C NMR Experiments. Gruyter 1984, 38, 333–342. [Google Scholar]
- Choi, J.W.; Faix, O. NMR study on residual lignins isolated from chemical pulps of beech wood by enzymatic hydrolysis. Ind. Eng. Chem. 2011, 17, 25–28. [Google Scholar] [CrossRef]
- Xie, Y.; Chen, X.; Zhao, H.; Jiang, C.; Wu, H.; Bi, S.; Ye, Z. Preparation of dehydrogenation polymer from isoeugenol and biological activity characterization. In Biochemistry Research Trends; Lu, F., Yue, F., Eds.; Nova Science Publishers Inc.: New York, NY, USA, 2019; pp. 281–296. [Google Scholar]
- Benhabiles, M.S.; Salah, R.; Lounici, H.; Drouiche, N.; Goosen, M.F.A.; Mameri, N. Antibacterial activity of chitin, chitosan and its oligomers prepared from shrimp shell waste. Food Hydrocoll. 2012, 29, 48–56. [Google Scholar] [CrossRef]
- Brown, J.S.; Mohamed, Z.J.; Artim, C.M.; Thornlow, D.N.; Hassler, J.F.; Rigoglioso, V.P.; Daniel, S.; Alabi, C.A. Antibacterial isoamphipathic oligomers highlight the importance of multimeric lipid aggregation for antibacterial potency. Commun. Biol. 2018, 1, 220. [Google Scholar] [CrossRef] [PubMed]
- Grace, J.L.; Schneider-Futschik, E.K.; Elliott, A.G.; Amado, M.; Truong, N.P.; Cooper, M.A.; Li, J.; Davis, T.P.; Quinn, J.F.; Velkov, T.; et al. Exploiting macromolecular design to optimize the antibacterial activity of alkylated cationic oligomers. Biomacromolecules 2018, 19, 4629–4640. [Google Scholar] [CrossRef]
- Shaikh, F.; Shastri, S.L.; Naik, N.S.; Kulkarni, R.; Madar, J.M.; Shastri, L.A.; Joshi, S.D.; Sunagar, D.V. Synthesis, Antitubercular and Antimicrobial Activity of 1,2,4-Triazolidine-3-thione Functionalized Coumarin and Phenyl Derivatives and Molecular Docking Studies. Chem. Chem. 2019, 4, 105–115. [Google Scholar] [CrossRef]
- Christofferson, A.J.; Elbourne, A.; Cheeseman, S.; Shi, Y.; Rolland, M.; Cozzolino, D.; Chapman, J.; McConville, C.F.; Crawford, R.J.; Wang, P.; et al. Conformationally tuned antibacterial oligomers target the peptidoglycan of Gram-positive bacteria. Colloid Interface Sci. 2020, 580, 850–862. [Google Scholar] [CrossRef]
- Senioa, S.; Pereira, C.; Vaz, J.; Sokovic, M.; Barros, L.; Ferreira, I.C.F.R. Dehydration process influences the phenolic profile, antiox idant and antimicrobial properties of Galium aparine L. Ind. Crops Prod. 2018, 120, 97–103. [Google Scholar] [CrossRef] [Green Version]
- Xie, Y.; Chen, X.; Jiang, C.; Wu, H.; Ye, Z. Preparation of oligomeric dehydrogenation polymer and characterization of its antibacterial properties. Bioresources 2019, 14, 2842–2860. [Google Scholar]
- Hattori, M.; Hada, S.; Watahiki, A.; Ihara, H.; Shu, Y.; Kakiuchi, N.; Mizuno, T.; Namba, T. Studies on dental caries prevention by traditional medicines. X. Antibacterial action of phenolic compounds from mace against Streptcoccus mutans. Chem. Pharm. Bull. 1986, 34, 3885–3893. [Google Scholar] [CrossRef] [Green Version]
- Dinev, Z.; Wardak, A.Z.; Brownlee, R.T.C.; Williams, S.J. A convenient gram-scale synthesis of uridine diphospho (13C6) glucose. Carbohydr. Res. 2006, 341, 1743–1747. [Google Scholar] [CrossRef] [PubMed]
- Wang, K.; Xu, F.; Sun, R. Molecular characteristics of kraft-AQ pulping lignin fractionated by sequential organic solvent extraction. Int. J. Mol. Sci. 2010, 11, 2988–3001. [Google Scholar] [CrossRef] [PubMed]
- Li, M.F.; Sun, S.N.; Xu, F.; Sun, R.C. Sequential solvent fractionation of heterogeneous bamboo organosolv lignin for value-added application. Sep. Purif. Technol. 2012, 101, 18–25. [Google Scholar] [CrossRef]
- Tan, C.; Kong, L.; Li, X.; Li, W.; Li, N. Isolation and analysis of a new phytoecdysteroid from Cyanotis arachnoidea C. B. Clarke. Chin. J. Chromatogr. 2011, 29, 937–941. [Google Scholar]
- Xiang, Y. Introduction of column chromatography for mixture separation. Chin. J. Chem. Educ. 2015, 36, 1–3. [Google Scholar]
- Carovic-Stanko, K.; Orlic, S.; Politeo, O.; Strikić, F.; Kolak, I.; Milos, M.; Satovic, Z. Composition and antibacterial activities of essential oils of seven Ocimum taxa. Food Chem. 2010, 119, 196–201. [Google Scholar] [CrossRef]
- Zhang, C.X.; Qiao, X.M.; Chen, H.W.; Zhang, Y.Y. Syntheses and Biological Activities of Lanthanide Metal Complexes with Nitronly Nitroxide. Synth. React. Inorg. Met. Org. Nano-Met. Chem. 2015, 45, 145–150. [Google Scholar] [CrossRef]
- Choi, O.; Cho, S.K.; Kim, J.; Park, C.G.; Kim, J. In vitro antibacterial activity and major bioactive components of Cinnamomum verum essential oils against cariogenic bacteria, Streptococcus mutans and Streptococcus sobrinus. Asian Pac. J. Trop. Biomed. 2016, 6, 308–314. [Google Scholar] [CrossRef] [Green Version]
- Jain, S.; Bhanjana, G.; Heydarifard, S.; Dilbaghi, N.; Nazhad, M.M.; Kumar, V.; Kim, K.; Kumar, S. Enhanced antibacterial profile of nanoparticle impregnated cellulose foam filter paper for drinking water filtration. Carbohydr. Polym. 2018, 202, 219–226. [Google Scholar] [CrossRef]
- Owuama, C.I. Determination of minimum inhibitory concentration (MIC) and minimum bactericidal concentration (MBC) using a novel dilution tube method. Afr. J. Microbiol. Res. 2017, 11, 977–980. [Google Scholar]
- Evtuguin, D.V.; Amado, F.M.L. Application of electrospray ionization mass spectrometry to the elucidation of the primary structure of lignin. Macromol. Biosci. 2003, 3, 339–343. [Google Scholar] [CrossRef]
- Reale, S.; Tullio, A.D.; Spreti, N.; Angelis, F.D. Mass spectrometry in the biosynthetic and structural investigation of lignins. Mass Spectrom. Rev. 2004, 23, 87–126. [Google Scholar] [CrossRef] [PubMed]
- Brecht, D.; Uteschil, F.; Schmitz, O.J. Development of a fast-switching dual (ESI/APCI) ionization source for liquid chromatography/mass spectrometry. Rapid Commun. Mass Spectrom. 2020, 34, e8845. [Google Scholar] [CrossRef] [PubMed]

| DHP Fractions | Mw | Mn | PDI |
|---|---|---|---|
| C11 | 289 | 192 | 1.51 |
| C12 | 619 | 387 | 1.60 |
| C13 | 1527 | 988 | 1.55 |
| C14 | 2846 | 1923 | 1.48 |
| C21 | 293 | 181 | 1.62 |
| C22 | 677 | 462 | 1.47 |
| C23 | 1478 | 860 | 1.72 |
| C24 | 2642 | 1794 | 1.47 |
Publisher’s Note: MDPI stays neutral with regard to jurisdictional claims in published maps and institutional affiliations. |
© 2022 by the authors. Licensee MDPI, Basel, Switzerland. This article is an open access article distributed under the terms and conditions of the Creative Commons Attribution (CC BY) license (https://creativecommons.org/licenses/by/4.0/).
Share and Cite
Wei, X.; Cui, S.; Xie, Y. Synthesis and Antibacterial Properties of Oligomeric Dehydrogenation Polymer from Lignin Precursors. Molecules 2022, 27, 1466. https://doi.org/10.3390/molecules27051466
Wei X, Cui S, Xie Y. Synthesis and Antibacterial Properties of Oligomeric Dehydrogenation Polymer from Lignin Precursors. Molecules. 2022; 27(5):1466. https://doi.org/10.3390/molecules27051466
Chicago/Turabian StyleWei, Xin, Sheng Cui, and Yimin Xie. 2022. "Synthesis and Antibacterial Properties of Oligomeric Dehydrogenation Polymer from Lignin Precursors" Molecules 27, no. 5: 1466. https://doi.org/10.3390/molecules27051466
APA StyleWei, X., Cui, S., & Xie, Y. (2022). Synthesis and Antibacterial Properties of Oligomeric Dehydrogenation Polymer from Lignin Precursors. Molecules, 27(5), 1466. https://doi.org/10.3390/molecules27051466

